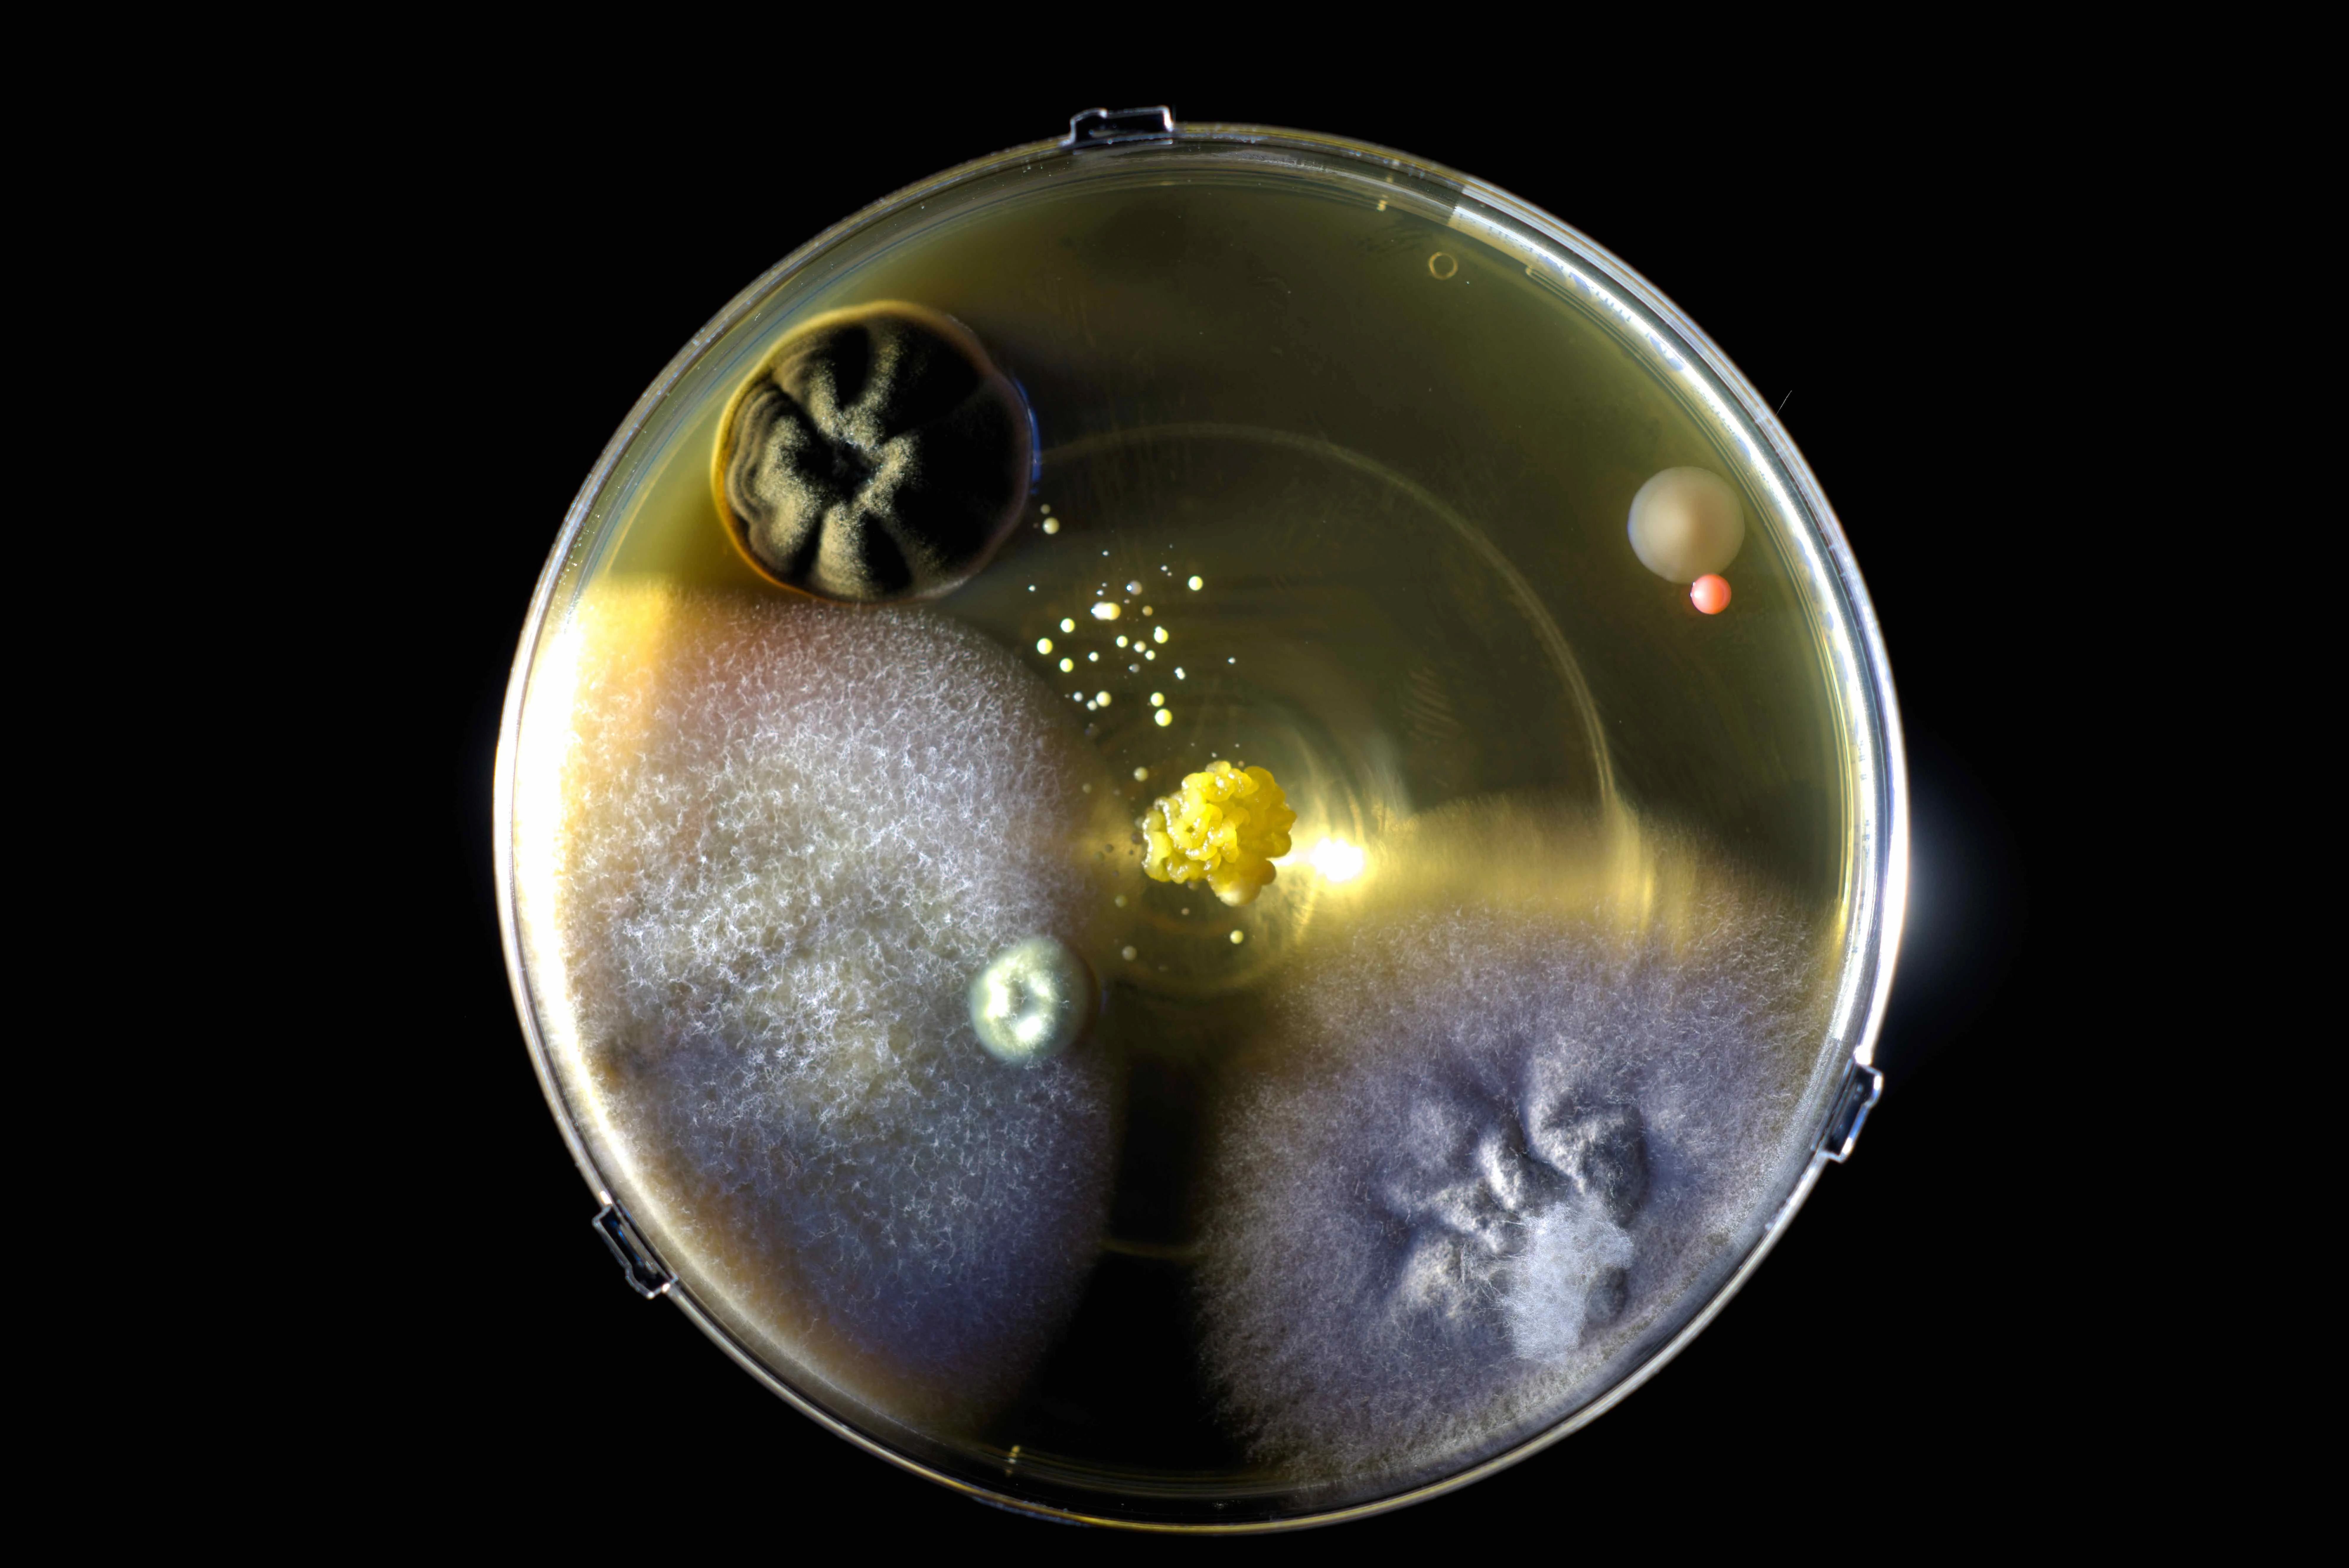

Pistez l'invisible : cinéma, performances et surprises artistiques sur les campus
-
24 mars 2026 > 25 mars 2026de 09:00 à 18:00Campus Tertrefalse false
-
Le 26 mars 2026 de 09:00 à 18:00Campus Lombarderiefalse false
-
24 & 25 mars de 9h à 18h sur le campus Tertre
26 mars de 9h à 18h sur le campus Lombarderie
Après deux ans de résidence artistique à Nantes université, le Collectif de la Meute s'installe une dernière fois sur les campus pour raconter joyeusement le chemin parcouru. À vous de pister leur caravane baleine, cinéma mobile et performances surprises pour explorer ce qui fait notre multitude et nous rend bien vivant·es.

Pistez les surprises artistiques sur les campus
Partez à la recherche de surprises artistiques disséminées sur vos campus pour découvrir récits intimes, expérimentations cinématographiques et performances artistiques autour des vivant·es qui peuplent nos corps et environnements.Au programme :
- Exposition sonore et visuelle : découvrez les portraits audios et micro-biotiens récoltés sur les campus
- Cinéma mobile : assistez à une projection de film en 7-8 mm accompagnés de fictions sonores
- Performances surprises : faites vous emporter par la musique et la danse, en symbiose avec les vivant.es
Mais aussi... Assistez au récit de cette exploration des vivant.es, mis en scène, au théâtre Francine Vasse - Les Laboratoires Vivants le 12 mars à 19h
Dans le cadre de la résidence Pister l'invisible

Nantes Université, par le biais de sa direction culture, a invité le Collectif de la Meute en immersion sur les campus pour une résidence d'artistes de deux ans. Avec des chercheur·es et étudiant·es comme complices, les artistes sont partis à la recherche de traces ou puissances d'agir insoupçonnées de notre quotidien.
La culture pour explorer nos liens aux vivant·es
L'exploration du Collectif de la Meute au sein de l'université se termine, mais la question de nos liens aux vivant.es continue d'exister au travers d'autres propositions artistiques et culturelles.Agenda
Exposition, concert, conférence... ne ratez rien des évènements de Nantes Université !
L'offre culturelle à Nantes Université
- Les ateliers de pratique
- Les Visites curieuses
- Le tarif Super Offert = 0€
- Résidences et créations partagées